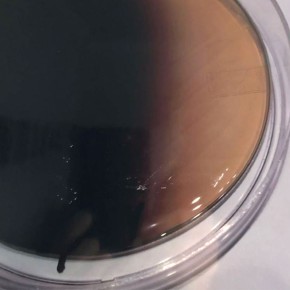
enterococcosal agar (20 pl.)

- Products
-
Products
- Laboratory
-
Devices for diagnostics
- Amblyopia screener & vision screener
- Audiometer
- Blood analysis devices
- Blood pressure monitors
- Dermatoscopes
- EEG
- ECG
- EMG
- Ergometer
- Fetal monitoring & CTG
- Vascular doppler
- Coagulation monitors
- Height & girth gauge
- Capnometers
- OAE screener
- Otoscopes & Ophthalmoscopes
- Pulse oximeters
- Vision screen boards
- Spirometers
- Stethoscopes
- Thermometer
- Tympanometer
- Ultrasound
- Vital signs monitors & patient monitors
- Scales
- Used equipment and special items
- Devices for therapy
- Catheters, stents and incontinence
- Consumables and practice needs
- Instruments
- Hygiene
- First aid, emergency equipment
- Doctor’s office equipment
- Couches, chairs and positioning aids
- Fertility medicine
- Personal Healthcare / Living healthy
- Software solutions
- Veterinary medicine
- Dental
- Service offerings
- more details: Products
- fastOrder
- Technical service
- Service offer
- About us
- Current
- FAQ
- Contact